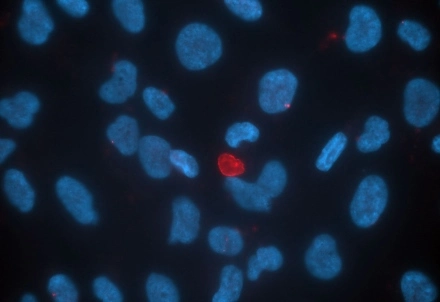

What do AI-enhanced satellite imaging, brook trout ecosystems, and sustainable energy partnerships have in common? They’re all topics that University of Winnipeg graduate students aced in 180 seconds flat during the 13th annual Three-Minute Thesis (3MT) Competition.
Twelve graduate students representing six different graduate programs competed in this year’s 3MT, which began with semi-finals on March 5. Six advanced to the final on March 19. When the timers had stopped and judges had deliberated, three students went home with trophies and a monetary prize.
3MT is a graduate-level research communication competition that originated in Australia in 2008. Each presenter has three minutes and a single, static slide to impress a general audience and a panel of judges by presenting their research in a compelling and accessible way.
Research in Focus offers a window into the research journey, capturing discovery in all its forms.
Dr. Jitendra Paliwal
“This year’s presentations were exceptionally polished and informative,” said Dr. Kyle Devine, Dean of the Faculty of Graduate Studies. “Our award recipients are hugely deserving, and all participants showcased the passion and dedication that define grad studies here at UWinnipeg. 3MT remains one of my favorite events on campus.”
Ishadie Namir, a MSc candidate in Applied Computer Science and Society competing in her first 3MT Competition, clinched the $2,000 first-place prize with “Seeing from Space: Helping AI Describe Satellite Images Accurately.” Ishadie’s research develops methods to help AI describe satellite images more accurately by teaching it to connect text and images through contrastive learning.
Imogen Bellinger, a MSc candidate in Bioscience, Technology and Public Policy, was awarded the $1,000 second-place prize for “Can They Cope? Testing the Limits of Brook Trout in a Changing Climate.” Imogen’s research examines how elevated temperature and carbon dioxide levels affect juvenile brook trout, and how scientists can use that information to mitigate the effects of climate change on aquatic ecosystems.
Tabitha Evans, a MA candidate in Environmental and Social Change, collected the $500 People’s Choice award for her presentation, “Powering Sustainable Energy Transitions Through Diversity.” Tabitha researches how integrated, transdisciplinary approaches can be harnessed to address complex environmental problems.
“Research in Focus offers a window into the research journey, capturing discovery in all its forms,” said Dr. Jitendra Paliwal, Vice-President, Research and Innovation. “By translating complex ideas into compelling visuals, it makes research more accessible and highlights its real-world impact, helping bridge the gap between discovery and public understanding.”
From seat to stage
Ishadie was inspired to enter 3MT after watching last year’s event as a spectator.
“I was really impressed by how each student was able to explain their research to an audience that wasn’t necessarily from their field,” she said. “That ability to make complex ideas accessible and engaging really inspired me, and it motivated me to take part this year and challenge myself to do the same.”
An international student from Bangladesh, Ishadie completed undergraduate studies in computer science prior to arriving at UWinnipeg, where she focuses on tackling real-world problems.
“My research focuses on developing machine learning approaches across diverse domains, including sea ice prediction, biological data analysis, and low-resource languages.”
She credited 3MT with helping her to see her research in a new light.
“The biggest takeaway for me was learning how to make my research inclusive and understandable to everyone, not just people in my field,” she explained. “It taught me the importance of communicating ideas in a way that allows anyone to understand what you’re doing. Also, I learned how to simplify complex research without losing its core meaning. Ultimately, this has helped me better understand how my research can benefit the community and the broader society around me.”
Ishadie will advance to the 3MT Western Regional Competition at the University of Regina on May 4, where she will compete alongside local finalists from 17 universities across Western Canada. Her summer will be spent on thesis research. After graduation, she plans to pursue a research-focused career in machine learning and AI.
“I’m particularly interested in roles that allow me to apply research to real-world problems, contribute to innovation, and collaborate with others to develop meaningful solutions that benefit society.”
Research photographers crowned
Winners of the third annual Research in Focus photography competition were also announced during 3MT.
Jasmyne Storm (MSc 25) was the competition’s biggest winner, collected four awards in total. “Turning Red,” which used fluorescent imaging to capture a red inflammasome against a sea of calm blue cells, won the grand prize and the Powered Perception category.
Storm’s entry “The Glia Club,” showing three student researchers in a lab environment, won the Faces of Discovery category. Storm’s “The Blur of Discovery” won the Best Description category.
The Viewer’s Choice award and first place in the Artistry in Research category went to Nadeesha Dissanayaka (MEnv 26), whose entry “Where Passion Meets Research” depicted lush evergreens reflected in a placid lakeshore in Whiteshell Provincial Park.
Maddalena Nowosad (BA Hons 23) won the Community Catalysts category for a photo taken at a Winnipeg event for women and 2SLGBTQIA+ skateboarders. The event coincided with Nowosad’s prize-winning research on increasing equity for marginalized skateboarders.
Taylor Cangemi, a bat researcher and Wesmen volleyball player who will graduate this spring from the Biology Honours program, won the Framing Fieldwork category with her entry, “Illuminating Emergence,” which depicts a harp trap, used to capture bats, at the entrance of an abandoned mine.
To view a full list of winners, runners-up, and entries from past competitions, visit the Research in Focus website.
Faculty awarded
The inaugural recipients of the new Faculty Award for Outstanding Graduate Mentorship were also announced during 3MT. Fittingly, the award was presented to two professors who are supervising 3MT winners: Dr. Caleb Hasler (Imogen Bellinger) and Dr. Sheela Ramanna (Ishadie Namir).